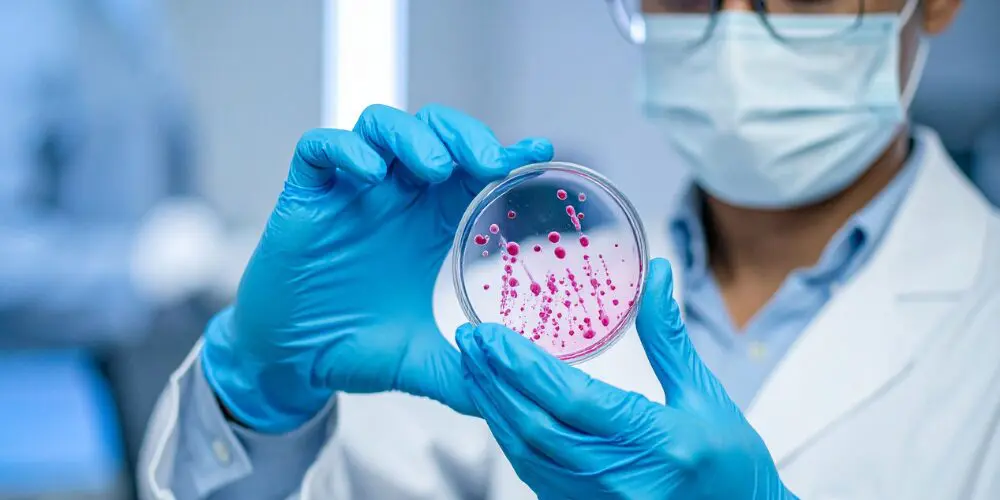

March 24, 2026
Optimism Returns to Life Science Funding and Partnerships in 2026
By Miguel Motta, Senior Vice President, Chief Operating Officer & Executive Director of San Diego, Biocom
As we wrap up the first quarter of 2026, the life science industry is beginning to find its footing after several years of volatility. Conversations with investors, pharmaceutical partners and emerging biotech companies point to a stabilizing environment that is increasingly defined by disciplined investment and a renewed emphasis on strategic partnerships as key drivers of growth.
Just weeks ago, industry leaders gathered at Biocom’s 16th annual Global Partnering & Investor Conference, widely recognized as the premier partnering and investment event for the life science ecosystem. The conference brought together venture capital firms, pharmaceutical companies, emerging biotechs and strategic partners for several days of partnering meetings, company presentations and panel discussions on the evolving investment environment. There, we were reminded that scientific differentiation continues to drive funding and partnerships and that “solid science” remains the primary driver of interest.
While capital deployment remains selective, the overall sentiment from investors and partners reflects cautious optimism heading into the remainder of 2026.
Capital Markets and Industry Momentum
Despite continued selectivity in venture funding, broader capital markets are showing signs of renewed momentum.
Total deal value across the life science sector reached $372 billion in 2025, a 47% year-over-year increase, reflecting renewed confidence in strategic dealmaking[1]. Healthcare venture investment also increased, reaching $60 billion across 2,167 deals, up from $54 billion across 2,121 deals in 2024[2].
Public markets are also beginning to reopen. The biotech sector has rebounded significantly over the past year. At the end of 2024, the median post-IPO performance for 18 VC-backed companies was –33%. That figure declined to –76% by mid-2025, with 16 of 18 companies trading below their IPO price. By year-end, however, 11 of those 18 companies were trading above their IPO price[2], signaling a meaningful shift in market sentiment.
We are observing more companies pursuing dual-track strategies, simultaneously exploring IPO opportunities while engaging potential strategic acquirers. Strong IPO momentum can strengthen negotiating leverage in acquisition discussions, while continued volatility in public markets may prompt pharmaceutical companies to engage earlier in strategic transactions.
Early 2026 Observations
Venture funding remains disciplined and increasingly concentrated in companies demonstrating clear clinical differentiation and well-defined regulatory pathways. Investors are placing greater emphasis on capital-efficient development strategies and focused pipelines.
At the same time, pharmaceutical companies continue to rely heavily on external innovation to replenish pipelines. While acquisition activity remains strong, buyers are applying greater rigor, prioritizing assets with clear ownership structures, compelling development data and straightforward commercialization pathways.
What We’re Seeing Across Our Membership
Beyond broader market trends, insights from our member companies highlight how organizations across the life science ecosystem are navigating the current environment. Across our membership, companies are entering the year focused on lean execution, capital efficiency, strategic partnerships and advancing key milestones.
Real estate conditions also remain a notable topic of discussion across the industry. According to Biocom member CBRE, construction activity is expected to decline further in 2026, with the life science construction pipeline reaching decade-low levels. Combined with stable demand, this dynamic is likely to support increased leasing activity. As supply and demand begin to rebalance, vacancy rates for lab/R&D properties across the top 13 markets declined in Q4 2025, the first decrease since 2022[3].
Despite ongoing market adjustments, the underlying strengths of the life science ecosystem remain clear: strong scientific innovation, active collaboration between emerging biotech companies and large pharmaceutical partners, and robust support from academic institutions, incubators and investors.
Looking Ahead
As the industry moves deeper into 2026, disciplined investment, strategic partnerships and scientific innovation will continue to define the next phase of growth in life science.
Even amid ongoing market fluctuations, the sector’s core drivers remain intact. Significant unmet medical needs persist, while advances in therapeutics, biologics and AI-enabled drug discovery are creating new pathways for innovation.
For companies navigating this environment, success will increasingly depend on clarity of science, alignment with the right partners and the ability to execute with discipline while delivering measurable progress toward meaningful patient outcomes.
[1] McKinsey & Company. (2026, February 13). Life sciences: Dealmaking gains momentum as strategic pressures intensify. https://www.mckinsey.com/capabilities/m-and-a/our-insights/life-sciences-dealmaking-gains-momentum-as-strategic-pressures-intensify
[2] Jonathan Norris. (2026, January 8). 2025 HSBC venture healthcare report. HSBC Innovation Banking. https://www.hsbcinnovationbanking.com/us/en/resources/2025-annual-venture-healthcare-report
[3] CBRE Research. (2026, March). 2026 U.S. Life Sciences Trends. https://mktgdocs.cbre.com/2299/8699b39e-5df2-4536-9aa6-6dc5613d904d-515628597/2026_US_Life_Sciences_Trends.pdf